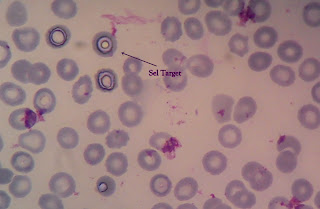

Pemeriksaan Feaces
- Makroskopis
Tujuan : Mengetahui keadaan faeces secara makroskopik meliputi konsistensi, warna, bau, sisa makanan, nanah (pus), darah, lendir dan parasit.
Alat dan bahan : Botol Penampung faeces
Spesimen : Faeces
Cara Kerja :
- Faeces yang didapat diamati keadaannya.
- Penilaian secara makroskopik mengenai konsistensi, warna, bau, sisa makanan, nanah/pus, darah, lendir dan adanya parasit di tempat yang terang cukup cahaya.
- Lakukan penilaian hasil pemeriksaan tersebut.
Nilai Normal :
- Konsistensi => Padat, encer, lembek (Normal : Padat, berbentuk)
- Warna => Merah, kuning, hijau, kuning kecoklatan, hitam, putih seperti lem (Normal : Kuning kecoklatan)
- Bau => Busuk, skatol, indol (Normal : Indol, Skatol)
- Sisa Makanan => Berminyak lemak, serat, kasar berbiji dan tidak tercerna (Normal : Ada serat)
- Lendir => Lendir banyak, lendir sedikit, lendir bercampur rata dengan darah, lendir putih, lendir merah. (Normal : Jumlah sedikit)
- Darah => Ada, ada bercampur merata, ada terpisah (Normal : Tidak ada)
- Pus / Nanah => Ada, banyak pus (Normal : Tidak ada)
- Parasit => Cacing dewasa, larva cacing, skolek, proglottid (Normal : Tidak ada)
- Mikroskipis
- Tanpa Pewarnaan (preparat basah dan kering)
- Pewarnaan Latar belakang
- Konsentrasi (khusus Telur cacing)
Tujuan : Untuk mengetahui keadaan faeces secara mikroskopik.
Alat dan Bahan :
Objek gelas
Cover gelas
Mikroskop
Pipet tetes
Lidi
Tabung
Pinset
Reagensia :
Parafin liquidum
Aquadest
Lugol 1%
Asam Asetat 30%
Sudan III
NaCl jenuh (konsentrasi)
Eosin 2%
Spesimen : Faeces
Cara Kerja :
- Tanpa Pewarnaan
- Dibuat 2 buah preparat, preparat pertama langsung diteteskan pada objek gelas dan ditutup cover gelas. Preparat kedua ditambah 1 tetes asam asetat 30% (untuk melihat sisa pencernaan protein), ditutup cover gelas dan diperiksa dimikroskop lensa objektif 10x dan 40x.
- Preparat Langsung (Sisa lemak)
- Diperiksa mikroskop lensa objektif 10x dan 40x.
- Dengan Pewarnaan
- 1 Tetes lugol 1% ditambah 1 bagian faeces
- Dicampur dan dipanaskan diatas nyala api kecil spritus selama 30 detik dan dinginkan, ditutup dengan cover gelas.
- Diperiksa mikroskop lensa objektif 10x dan 40x.
b) Sisa Pencernaan Lemak
- 1 Tetes Sudan III ditambah 1 tetes asam asetat dan 1 bagian faeces
- Dicampur dan dipanaskan diatas nyala api kecil spritus selama 30 detik dan dinginkan, ditutup dengan cover gelas.
- Diperiksa mikroskop lensa objektif 10x dan 40x.
c) Adanya Eritrosit, Leukosit dan Amoeba
- 1 tetes Eosin 2% ditambah 1 bagian faeces dan dicampur.
- Ditutup dengan cover gelas dan diperiksa mikroskop lensa objektif 10x dan 40x.
4. Konsentrasi
- 5 gram faeces dicampur dengan NaCl jenuh 3-5 mL dalam beaker gelas
- Diaduk sampai merata hingga terbentuk suspensi.
- Diapungkan cover gelas dipermukaan suspensi selama 30 -60 menit.
- Diambil cover gelas dengan pinset dan diletakkan di atas objek gelas.
- Diperiksa mikroskop lensa objektif 10x dan 40x.
- KIMIAWI
Darah Samar
Metode : Benzidine
Tujuan : Untuk mengetahui adanya darah samar dalam faeces.
Prinsip : Darah mengandung enzim peroksidase yang akan menguraikan hidrogen peroksida dalam suasana asam sehingga akan mengoksidasi benzidine menjadi senyawa yang berwarna hijau biru.
Alat dan Bahan :
Tabung reaksi
Lampu spritus
Pipet tetes
Batang pengaduk
Reagensia :
Larutan Benzidine jenuh
Asam asetat glasial
Larutan Hidrogen peroksida 3%
Spesimen : faeces
Cara Kerja :
- tabung reaksi I : masukkan sepucuk sendok benzidine.
- Tambahkan 3 tetes asam asetat glasial dan kocok.
- Ditambah 20 tetes H2O2 3% dan dicampur hingga homogen.
- Tabung reaksi II : Faeces disuspensikan menggunakan air atau aquadest dan dipanaskan nyala api kecil. Dinginkan.
- Dicampur tabung I ke tabung II dan diamkan selama 5 menit.
- Dibaca hasilnya.
Penilaian sama dengan darah samar dalam feaces :
- Hasil negatif (-) bila larutan tetap coklat
- Hasil positif (+) bila larutan coklat kemerahan
Sterkobilin
Metode : Schmidt
Tujuan : Untuk mengetahui adanya sterkobilin dalam faeces.
Prinsip : Urobilin/sterkobilin bereaksi dengan sublimat membentuk zat warna merah.
Alat dan Bahan :
Tabung reaksi
Lampu spritus
Pipet tetes
Reagensia :
Larutan jenuh Sublimat (HgCl2)
Spesimen : Faeces
Cara Kerja :
- 3 gram faeces atau sepucuk sendok dicampur dengan 4-5 mL larutan sublimat jenuh.
- Diaduk agar tercampur.
- Dipanaskan sampai mendidih dan dinginkan.
- Dibaca hasilnya.
Penilaian Hasil :
Adanya sterkobilin terbentuk warna merah.
Sel Erytrosit dalam Faeces
Sel Tumbuhan
Sumber :
foto diambil dengan menggunakan kamera hp wktu praktek Kimia Klinik kamis kemaren :)